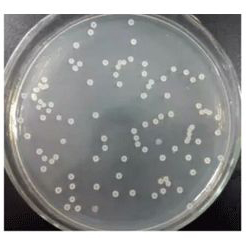
北纳创联酸土脂环酸芽孢杆菌

万千商家帮你免费找货
0 人在求购买到急需产品
- 详细信息
- 文献和实验
- 技术资料
- 供应商:
北纳创联
- 英文名:
Alicyclobacillus acidoterrestris
- 保质期:
1-2年
| 基本信息 | |
| 资源编号 | BNCC185276 |
| 其它编号 | =ACCC10223=DSM3922=ATCC49025 |
| 资源名称 | 酸土脂环酸芽孢杆菌 |
| 种属 | Alicyclobacillus acidoterrestris |
| 分离基物 | 花园土壤 |
| 提供形式 | 冻干物 |
| 安全等级 | 1 |
| 模式菌株 | yes |
| 应用领域 | 分类学研究,质量控制。 |
| 培养方法 | |
| 培养基 | CM0437 |
| 生长条件 | 45-50℃ |
| 存储条件 | -80℃冰箱冻结法;真空冷冻干燥法 |
| 详细说明 | |
| 描述 | G+,细胞呈直杆状,0.53um×2.33~3.67um,芽孢卵圆形,孢囊膨大。 |
风险提示:丁香通仅作为第三方平台,为商家信息发布提供平台空间。用户咨询产品时请注意保护个人信息及财产安全,合理判断,谨慎选购商品,商家和用户对交易行为负责。对于医疗器械类产品,请先查证核实企业经营资质和医疗器械产品注册证情况。
 文献和实验
文献和实验5cm的表层土由于阳光照射,蒸发量大,水分少,且有紫外线的杀菌作用,因而微生物数量比5~25cm土层少;25cm以下土层则因土质紧密,空气量不足,养分与水分缺乏,含菌量也逐步减少。因此,采土样最好的土层是5~25cm。一般每克土中含菌数约几十万到几十亿个,并且各种类型的细菌和放线菌几乎都能分离到。如好气芽孢杆菌、假单胞菌、短杆菌、大肠杆菌、某些嫌气菌等。但总的说来酵母菌分布土层最浅,约5~10cm,霉菌和好氧芽孢杆菌也分布在浅土层。 2.土壤酸碱度和植被状况 土壤酸碱度会影响微生物种类的分布
制作方法与配方 一、【EM原液发酵方法】 :制作EM菌种发酵液——EM原液 A、菌种活化:用EM菌种10克、红糖0.1公斤(红糖先用热水溶化),加入1公斤的水。注:(先把水加热到100°C后加入红塘或白糖,而后继续加热5分钟。冷却到40°C时加入EM菌种),密闭发酵(35°C-37°C温度)下发酵3-5天,第3天可以放气一次!打开容器口闻到有酸甜味即活化
经富集培养以后的样品,目的微生物得到增殖,占了优势,其他种类的微生物在数量上相对减少,但并未死亡。富集后的培养液中仍然有多种微生物混杂在一起,即使占了优势的一类微生物中,也并非纯种。例如同样一群以油脂为碳源的脂肪酶产生菌,有的是细菌,有的是霉菌,有的是芽孢杆菌,有的不产芽孢,有的生产能力强,有的生产能力弱等等。因此,经过富集培养后的样品,也需要进一步通过分离纯化,把最需要的菌株直接从样品中分离出来。一、好气微生物的分离分离的方法很多,大体可分为两类:一类较为粗放,只能达到“菌落纯”,如稀释涂布
 技术资料
技术资料暂无技术资料 索取技术资料